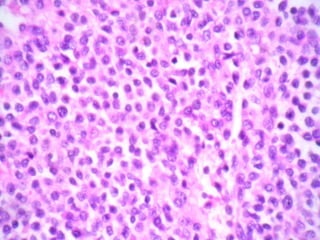
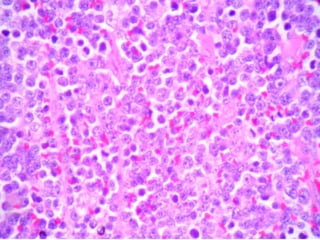
Slide seminar 3

Embed presentation
Download to read offline




















A 55-year-old female presented with pancytopenia and spleenomegaly. Bone marrow aspiration was dry but imprint smears and biopsy showed relevant findings. A 30-year-old male presented with upper GI obstruction and was found to have an ulcerative duodenal lesion. He underwent Whipple's operation and imaging found enlarged pancreaticoduodenal and paraaortic nodes with mild hepatosplenomegaly. Micrographs of lymph nodes were submitted. A 65-year-old male presented with abdominal discomfort and CT scan showed multiple enlarged retroperitoneal and mesenteric nodes without hepatosplenomegaly; a biopsy of a retroperitoneal lymph node was submitted.